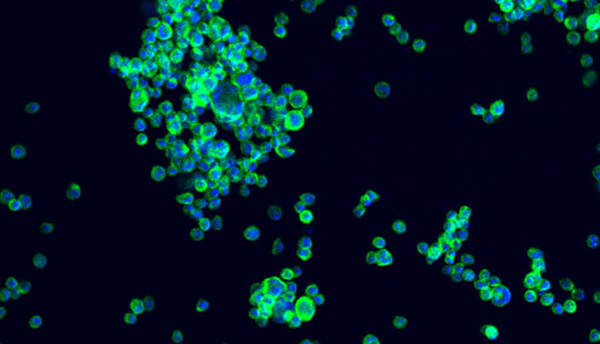
A microscope image of NISTCHO cells that are stained blue and green on a black background..

NIST’s ‘Living Reference Material’ Could Accelerate R&D of Lifesaving Biological Drugs
A type of drug called monoclonal antibodies (mAbs) can halt the growth of breast tumors, block the effects of rheumatoid arthritis, and treat many other diseases, from leukemia and colon cancer to asthma and osteoporosis. To manufacture these drugs, pharmaceutical companies genetically engineer living cells, grow those cells in large bioreactors, and harvest the mAb proteins that the cells produce.
To support the manufacturing of these drugs, researchers at the National Institute of Standards and Technology (NIST) have collaborated with biotech company MilliporeSigma and the National Institute for Innovation in Manufacturing Biopharmaceuticals (NIIMBL) to develop a “living” reference material: specially tailored living cells that make mAbs with well-known properties.
|